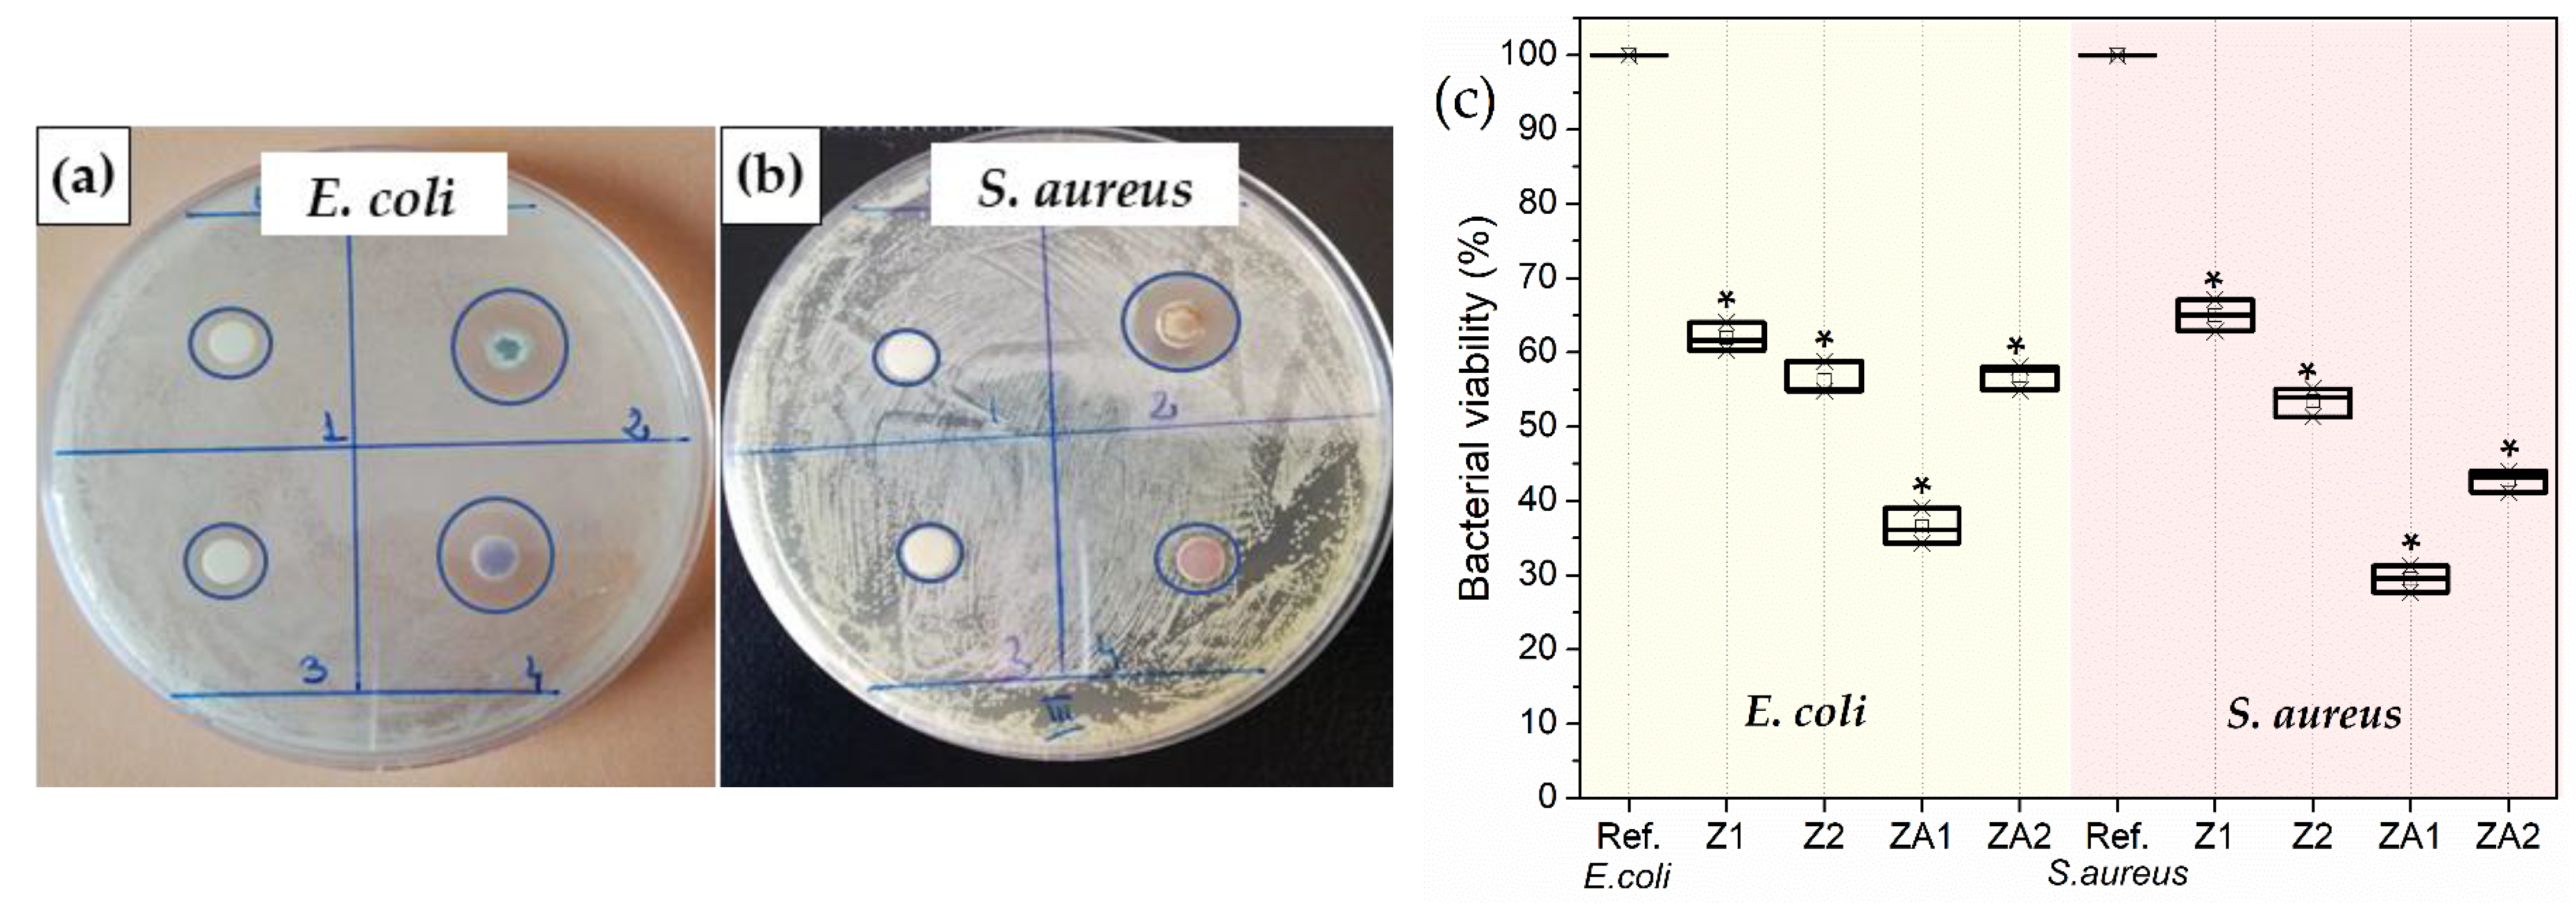
Nanomaterials 12 03832 g005 Nanomaterials 12 03832 g005

Synthesis of ZnO/Au Nanocomposite for Antibacterial Applications
Abstract
1. Introduction
2. Materials and Methods
2.1. Materials
2.2. ZnO and Zn/Au Synthesis
2.2.1. ZnO Synthesis
2.2.2. ZnO/Au Synthesis
2.3. Characterisation Techniques
2.4. Antibacterial Activity
2.4.1. Disc Diffusion Assay
2.4.2. Tetrazolium/Formazan (TTC) Assay
2.5. Statistical Analysis
3. Results and Discussion
3.1. Structure and Morphology of ZnO Nanostructures
3.2. Antibacterial Activity
4. Conclusions
Supplementary Materials
Author Contributions
Funding
Data Availability Statement
Acknowledgments
Conflicts of Interest
References
- Haddaji, N.; Environmental contaminants and antibiotic resistance as a One Health threat. One Health. Elsevier: Amsterdam, The Netherlands, 2022; pp. 231–252. [Google Scholar]
- Available online: https://www.who.int/news-room/spotlight/10-global-health-issues-to-track-in-2021 (accessed on 24 October 2022).
- O’Neill, J. Tackling Drug-Resistant Infections Globally: Final Report and Recommendations. Available online: https://amr-review.org/sites/default/files/160518_Final%20paper_with%20cover.pdf (accessed on 24 October 2022).
- Venter, H.; Henningsen, M.L.; Begg, S.L. Antimicrobial resistance in healthcare, agriculture and the environment: The biochemistry behind the headlines. Essays Biochem. 2017, 61, 1–10. [Google Scholar] [CrossRef] [PubMed]
- Weldick, P.J.; Wang, A.; Halbus, A.F.; Paunov, V.N. Emerging nanotechnologies for targeting antimicrobial resistance. Nanoscale 2022, 14, 4018–4041. [Google Scholar] [CrossRef] [PubMed]
- Pasquet, J.; Chevalier, Y.; Pelletier, J.; Couval, E.; Bouvier, D.; Bolzinger, M.-A. The contribution of zinc ions to the antimicrobial activity of zinc oxide. Colloids Surf. A Physicochem. Eng. Asp. 2014, 457, 263–274. [Google Scholar] [CrossRef]
- Nel, A.E.; Mädler, L.; Velegol, D.; Xia, T.; Hoek, E.M.; Somasundaran, P.; Klaessig, F.; Castranova, V.; Thompson, M. Understanding biophysicochemical interactions at the nano–bio interface. Nat. Mater. 2009, 8, 543–557. [Google Scholar] [CrossRef] [PubMed]
- Hajipour, M.J.; Fromm, K.M.; Ashkarran, A.A.; de Aberasturi, D.J.; de Larramendi, I.R.; Rojo, T.; Serpooshan, V.; Parak, W.J.; Mahmoudi, M. Antibacterial properties of nanoparticles. Trends Biotechnol. 2012, 30, 499–511. [Google Scholar] [CrossRef]
- Wang, L.; Hu, C.; Shao, L. The antimicrobial activity of nanoparticles: Present situation and prospects for the future. Int. J. Nanomed. 2017, 12, 1227. [Google Scholar] [CrossRef]
- Walvekar, P.; Gannimani, R.; Govender, T. Combination drug therapy via nanocarriers against infectious diseases. Eur. J. Pharm. Sci. 2019, 127, 121–141. [Google Scholar] [CrossRef]
- Pelgrift, R.Y.; Friedman, A.J. Nanotechnology as a therapeutic tool to combat microbial resistance. Adv. Drug Deliv. Rev. 2013, 65, 1803–1815. [Google Scholar] [CrossRef]
- Gatoo, M.A.; Naseem, S.; Arfat, M.Y.; Mahmood Dar, A.; Qasim, K.; Zubair, S. Physicochemical Properties of Nanomaterials: Implication in Associated Toxic Manifestations. BioMed Res. Int. 2014, 2014, 498420. [Google Scholar] [CrossRef]
- Song, H.; Ko, K.; Oh, L.; Lee, B. Fabrication of silver nanoparticles and their antimicrobial mechanisms. Eur Cells Mater 2006, 11 (Suppl. 1), 58. [Google Scholar]
- Kędziora, A.; Wieczorek, R.; Speruda, M.; Matolínová, I.; Goszczyński, T.M.; Litwin, I.; Matolín, V.; Bugla-Płoskońska, G. Comparison of antibacterial mode of action of silver ions and silver nanoformulations with different physico-chemical properties: Experimental and computational studies. Front. Microbiol. 2021, 12, 1707. [Google Scholar] [CrossRef] [PubMed]
- Dincă, V.; Mocanu, A.; Isopencu, G.; Busuioc, C.; Brajnicov, S.; Vlad, A.; Icriverzi, M.; Roseanu, A.; Dinescu, M.; Stroescu, M. Biocompatible pure ZnO nanoparticles-3D bacterial cellulose biointerfaces with antibacterial properties. Arab. J. Chem. 2018, 13, 3521–3533. [Google Scholar] [CrossRef]
- Sharma, D.; Sharma, S.; Kaith, B.S.; Rajput, J.; Kaur, M. Synthesis of ZnO nanoparticles using surfactant free in-air and microwave method. Appl. Surf. Sci. 2011, 257, 9661–9672. [Google Scholar] [CrossRef]
- Kumar, K.; Priya, A.; Arun, A.; Hait, S.; Chowdhury, A. Antibacterial and natural room-light driven photocatalytic activities of CuO nanorods. Mater. Chem. Phys. 2019, 226, 106–112. [Google Scholar] [CrossRef]
- Verma, V.; Al-Dossari, M.; Singh, J.; Rawat, M.; Kordy, M.G.; Shaban, M. A Review on Green Synthesis of TiO2 NPs: Photocatalysis and Antimicrobial Applications. Polymers 2022, 14, 1444. [Google Scholar] [CrossRef]
- Joharian, M.; Mojarab, M.; Darvishi, E.; Khosravi, H.; Nazari, V.; Varnamkhasti, B.S.; Mirsadeghi, S. Green synthesis of biogenic Cu/Fe3O4 nanocomposite using the Eriobotrya japonica seed extract against pathogenic bacteria. J. Mol. Struct. 2022, 1264, 133229. [Google Scholar] [CrossRef]
- Alavi, M.; Hamblin, M.R.; Mozafari, M.; Rose Alencar De Menezes, I.; Douglas Melo Coutinho, H. Surface modification of SiO2 nanoparticles for bacterial decontaminations of blood products. Cell. Mol. Biomed. Rep. 2022, 2, 87–97. [Google Scholar] [CrossRef]
- Amiri, A.; Zardini, H.Z.; Shanbedi, M.; Maghrebi, M.; Baniadam, M.; Tolueinia, B. Efficient method for functionalization of carbon nanotubes by lysine and improved antimicrobial activity and water-dispersion. Mater. Lett. 2012, 72, 153–156. [Google Scholar] [CrossRef]
- Ding, X.; Yuan, P.; Gao, N.; Zhu, H.; Yang, Y.Y.; Xu, Q.-H. Au-Ag core-shell nanoparticles for simultaneous bacterial imaging and synergistic antibacterial activity. Nanomed. Nanotechnol. Biol. Med. 2017, 13, 297–305. [Google Scholar] [CrossRef]
- Piktel, E.; Suprewicz, Ł.; Depciuch, J.; Chmielewska, S.; Skłodowski, K.; Daniluk, T.; Król, G.; Kołat-Brodecka, P.; Bijak, P.; Pajor-Świerzy, A. Varied-shaped gold nanoparticles with nanogram killing efficiency as potential antimicrobial surface coatings for the medical devices. Sci. Rep. 2021, 11, 1–20. [Google Scholar] [CrossRef]
- Gunalan, S.; Sivaraj, R.; Rajendran, V. Green synthesized ZnO nanoparticles against bacterial and fungal pathogens. Prog. Nat. Sci. Mater. Int. 2012, 22, 693–700. [Google Scholar] [CrossRef]
- Kaushik, M.; Niranjan, R.; Thangam, R.; Madhan, B.; Pandiyarasan, V.; Ramachandran, C.; Oh, D.-H.; Venkatasubbu, G.D. Investigations on the antimicrobial activity and wound healing potential of ZnO nanoparticles. Appl. Surf. Sci. 2019, 479, 1169–1177. [Google Scholar] [CrossRef]
- Dyshlyuk, L.; Babich, O.; Ivanova, S.; Vasilchenco, N.; Atuchin, V.; Korolkov, I.; Russakov, D.; Prosekov, A. Antimicrobial potential of ZnO, TiO2 and SiO2 nanoparticles in protecting building materials from biodegradation. Int. Biodeterior. Biodegrad. 2020, 146, 104821. [Google Scholar] [CrossRef]
- Taghizadeh, S.-M.; Lal, N.; Ebrahiminezhad, A.; Moeini, F.; Seifan, M.; Ghasemi, Y.; Berenjian, A. Green and economic fabrication of zinc oxide (ZnO) nanorods as a broadband UV blocker and antimicrobial agent. Nanomaterials 2020, 10, 530. [Google Scholar] [CrossRef] [PubMed]
- Umar, A.; Chauhan, M.; Chauhan, S.; Kumar, R.; Sharma, P.; Tomar, K.J.; Wahab, R.; Al-Hajry, A.; Singh, D. Applications of ZnO nanoflowers as antimicrobial agents for Escherichia coli and enzyme-free glucose sensor. J. Biomed. Nanotechnol. 2013, 9, 1794–1802. [Google Scholar] [CrossRef] [PubMed]
- Thakur, S.; Kaur, M.; Lim, W.F.; Lal, M. Fabrication and characterization of electrospun ZnO nanofibers; antimicrobial assessment. Mater. Lett. 2020, 264, 127279. [Google Scholar] [CrossRef]
- Buşilă, M.; Muşat, V.; Textor, T.; Mahltig, B. Synthesis and characterization of antimicrobial textile finishing based on Ag: ZnO nanoparticles/chitosan biocomposites. Rsc Adv. 2015, 5, 21562–21571. [Google Scholar] [CrossRef]
- Pathak, T.K.; Kroon, R.; Craciun, V.; Popa, M.; Chifiriuc, M.; Swart, H. Influence of Ag, Au and Pd noble metals doping on structural, optical and antimicrobial properties of zinc oxide and titanium dioxide nanomaterials. Heliyon 2019, 5, e01333. [Google Scholar] [CrossRef]
- da Silva, B.L.; Caetano, B.L.; Chiari-Andréo, B.G.; Pietro, R.C.L.R.; Chiavacci, L.A. Increased antibacterial activity of ZnO nanoparticles: Influence of size and surface modification. Colloids Surf. B: Biointerfaces 2019, 177, 440–447. [Google Scholar] [CrossRef]
- Lotfiman, S.; Ghorbanpour, M. Antimicrobial activity of ZnO/silica gel nanocomposites prepared by a simple and fast solid-state method. Surf. Coat. Technol. 2017, 310, 129–133. [Google Scholar] [CrossRef]
- Piedade, A.; Pinho, A.; Branco, R.; Morais, P. Evaluation of antimicrobial activity of ZnO based nanocomposites for the coating of non-critical equipment in medical-care facilities. Appl. Surf. Sci. 2020, 513, 145818. [Google Scholar] [CrossRef]
- Esparza-González, S.; Sánchez-Valdés, S.; Ramírez-Barrón, S.; Loera-Arias, M.; Bernal, J.; Meléndez-Ortiz, H.I.; Betancourt-Galindo, R. Effects of different surface modifying agents on the cytotoxic and antimicrobial properties of ZnO nanoparticles. Toxicol. Vitr. 2016, 37, 134–141. [Google Scholar] [CrossRef]
- Khane, Y.; Benouis, K.; Albukhaty, S.; Sulaiman, G.M.; Abomughaid, M.M.; Al Ali, A.; Aouf, D.; Fenniche, F.; Khane, S.; Chaibi, W. Green Synthesis of Silver Nanoparticles Using Aqueous Citrus limon Zest Extract: Characterization and Evaluation of Their Antioxidant and Antimicrobial Properties. Nanomaterials 2022, 12, 2013. [Google Scholar] [CrossRef] [PubMed]
- Huq, M.A.; Ashrafudoulla, M.; Rahman, M.M.; Balusamy, S.R.; Akter, S. Green synthesis and potential antibacterial applications of bioactive silver nanoparticles: A review. Polymers 2022, 14, 742. [Google Scholar] [CrossRef] [PubMed]
- Deeksha, B.; Sadanand, V.; Hariram, N.; Rajulu, A.V. Preparation and properties of cellulose nanocomposite fabrics with in situ generated silver nanoparticles by bioreduction method. J. Bioresour. Bioprod. 2021, 6, 75–81. [Google Scholar] [CrossRef]
- Yorseng, K.; Siengchin, S.; Ashok, B.; Rajulu, A.V. Nanocomposite egg shell powder with in situ generated silver nanoparticles using inherent collagen as reducing agent. J. Bioresour. Bioprod. 2020, 5, 101–107. [Google Scholar] [CrossRef]
- Zhang, Y.; Shareena Dasari, T.P.; Deng, H.; Yu, H. Antimicrobial activity of gold nanoparticles and ionic gold. J. Environ. Sci. Health Part C 2015, 33, 286–327. [Google Scholar] [CrossRef]
- Okkeh, M.; Bloise, N.; Restivo, E.; De Vita, L.; Pallavicini, P.; Visai, L. Gold nanoparticles: Can they be the next magic bullet for multidrug-resistant bacteria? Nanomaterials 2021, 11, 312. [Google Scholar] [CrossRef]
- Zhao, X.; Tang, H.; Jiang, X. Deploying Gold Nanomaterials in Combating Multi-Drug-Resistant Bacteria. ACS Nano 2022, 16, 10066–10087. [Google Scholar] [CrossRef]
- Qiao, Z.; Yao, Y.; Song, S.; Yin, M.; Yang, M.; Yan, D.; Yang, L.; Luo, J. Gold nanorods with surface charge-switchable activities for enhanced photothermal killing of bacteria and eradication of biofilm. J. Mater. Chem. B 2020, 8, 3138–3149. [Google Scholar] [CrossRef]
- Zhang, R.; Yu, J.; Ma, K.; Ma, Y.; Wang, Z. Synergistic Chemo-Photothermal Antibacterial Effects of Polyelectrolyte-Functionalized Gold Nanomaterials. ACS Appl. Bio Mater. 2020, 3, 7168–7177. [Google Scholar] [CrossRef]
- Borzenkov, M.; Pallavicini, P.; Taglietti, A.; D’Alfonso, L.; Collini, M.; Chirico, G. Photothermally active nanoparticles as a promising tool for eliminating bacteria and biofilms. Beilstein J. Nanotechnol. 2020, 11, 1134–1146. [Google Scholar] [CrossRef] [PubMed]
- Jiménez, A.B.P.; Aguilar, C.A.H.; Ramos, J.M.V.; Thangarasu, P. Synergistic antibacterial activity of nanohybrid materials ZnO–Ag and ZnO–Au: Synthesis, characterization, and comparative analysis of undoped and doped ZnO nanoparticles. Aust. J. Chem. 2015, 68, 288–297. [Google Scholar] [CrossRef]
- Liu, B.; Zeng, H.C. Hydrothermal synthesis of ZnO nanorods in the diameter regime of 50 nm. J. Am. Chem. Soc. 2003, 125, 4430–4431. [Google Scholar] [CrossRef] [PubMed]
- Eloff, J.N. A sensitive and quick microplate method to determine the minimal inhibitory concentration of plant extracts for bacteria. Planta Med. 1998, 64, 711–713. [Google Scholar] [CrossRef] [PubMed]
- Dediu, V.; Musat, V.; Cernica, I. Nb-TiO2/ZnO nanostructures for chemoresistive alcohol sensing. Appl. Surf. Sci. 2019, 488, 70–76. [Google Scholar] [CrossRef]
- Cheng, B.; Samulski, E.T. Hydrothermal synthesis of one-dimensional ZnO nanostructures with different aspect ratios. Chem. Commun. 2004, 8, 986–987. [Google Scholar] [CrossRef]
- Hu, L.; Dong, S.; Li, Q.; Li, Y.; Pi, Y.; Liu, M.; Han, X.; Sun, J. Effects of sodium dodecyl benzene sulfonate on the crystal structures and photocatalytic performance of ZnO powders prepared by hydrothermal method. J. Alloy. Compd. 2015, 649, 400–408. [Google Scholar] [CrossRef]
- Šarić, A.; Despotović, I.; Štefanić, G. Alcoholic solvent influence on ZnO synthesis: A joint experimental and theoretical study. J. Phys. Chem. C 2019, 123, 29394–29407. [Google Scholar] [CrossRef]
- Yoshimura, M.; Byrappa, K. Hydrothermal processing of materials: Past, present and future. J. Mater. Sci. 2008, 43, 2085–2103. [Google Scholar] [CrossRef]
- Xu, L.; Hu, Y.-L.; Pelligra, C.; Chen, C.-H.; Jin, L.; Huang, H.; Sithambaram, S.; Aindow, M.; Joesten, R.; Suib, S.L. ZnO with different morphologies synthesized by solvothermal methods for enhanced photocatalytic activity. Chem. Mater. 2009, 21, 2875–2885. [Google Scholar] [CrossRef]
- Elavazhagan, T.; Arunachalam, K.D. Memecylon edule leaf extract mediated green synthesis of silver and gold nanoparticles. Int. J. Nanomed. 2011, 6, 1265. [Google Scholar] [CrossRef] [PubMed]
- Vergés, M.A.; Mifsud, A.; Serna, C. Formation of rod-like zinc oxide microcrystals in homogeneous solutions. J. Chem. Soc. Faraday Trans. 1990, 86, 959–963. [Google Scholar] [CrossRef]
- Zak, A.K.; Abrishami, M.E.; Majid, W.A.; Yousefi, R.; Hosseini, S. Effects of annealing temperature on some structural and optical properties of ZnO nanoparticles prepared by a modified sol–gel combustion method. Ceram. Int. 2011, 37, 393–398. [Google Scholar] [CrossRef]
- Zak, A.K.; Razali, R.; Abd Majid, W.H.; Darroudi, M. Synthesis and characterization of a narrow size distribution of zinc oxide nanoparticles. Int. J. Nanomed. 2011, 6, 1399. [Google Scholar]
- Dubey, N. Thermodynamic and FT-IR study of micellization of sodium dodecylbenzene sulfonate in some simple alcohols. Chem. Eng. Commun. 2011, 198, 1394–1404. [Google Scholar] [CrossRef]
- Kaur, I.; Ellis, L.-J.; Romer, I.; Tantra, R.; Carriere, M.; Allard, S.; Mayne-L’Hermite, M.; Minelli, C.; Unger, W.; Potthoff, A. Dispersion of nanomaterials in aqueous media: Towards protocol optimization. JoVE (J. Vis. Exp.) 2017, 130, e56074. [Google Scholar] [CrossRef]
- Modena, M.M.; Rühle, B.; Burg, T.P.; Wuttke, S. Nanoparticle Characterization: Nanoparticle Characterization: What to Measure?(Adv. Mater. 32/2019). Adv. Mater. 2019, 31, 1970226. [Google Scholar] [CrossRef]
- Wangoo, N.; Kaur, S.; Bajaj, M.; Jain, D.; Sharma, R.K. One pot, rapid and efficient synthesis of water dispersible gold nanoparticles using alpha-amino acids. Nanotechnology 2014, 25, 435608. [Google Scholar] [CrossRef]
- Selvakannan, P.; Mandal, S.; Phadtare, S.; Pasricha, R.; Sastry, M. Capping of gold nanoparticles by the amino acid lysine renders them water-dispersible. Langmuir 2003, 19, 3545–3549. [Google Scholar] [CrossRef]
- Braissant, O.; Astasov-Frauenhoffer, M.; Waltimo, T.; Bonkat, G. A review of methods to determine viability, vitality, and metabolic rates in microbiology. Frontiers in Microbiology 2020, 11, 547458. [Google Scholar] [CrossRef] [PubMed]
- Kragh, K.N.; Alhede, M.; Rybtke, M.; Stavnsberg, C.; Jensen, P.Ø.; Tolker-Nielsen, T.; Whiteley, M.; Bjarnsholt, T. The inoculation method could impact the outcome of microbiological experiments. Appl.Environ. Microb. 2018, 84, e02264-17. [Google Scholar] [CrossRef] [PubMed]
- Moussa, S.H.; Tayel, A.A.; Al-Hassan, A.A.; Farouk, A. Tetrazolium/formazan test as an efficient method to determine fungal chitosan antimicrobial activity. J. Mycol. 2013, 2013, 753692. [Google Scholar] [CrossRef]
- Huang, Z.; Zheng, X.; Yan, D.; Yin, G.; Liao, X.; Kang, Y.; Yao, Y.; Huang, D.; Hao, B. Toxicological effect of ZnO nanoparticles based on bacteria. Langmuir 2008, 24, 4140–4144. [Google Scholar] [CrossRef] [PubMed]
- Zhang, L.; Jiang, Y.; Ding, Y.; Povey, M.; York, D. Investigation into the antibacterial behaviour of suspensions of ZnO nanoparticles (ZnO nanofluids). J. Nanoparticle Res. 2007, 9, 479–489. [Google Scholar] [CrossRef]
- Linklater, D.P.; Baulin, V.A.; Le Guével, X.; Fleury, J.B.; Hanssen, E.; Nguyen, T.H.P.; Juodkazis, S.; Bryant, G.; Crawford, R.J.; Stoodley, P. Antibacterial action of nanoparticles by lethal stretching of bacterial cell membranes. Adv. Mater. 2020, 32, 2005679. [Google Scholar] [CrossRef]
- Raghupathi, K.R.; Koodali, R.T.; Manna, A.C. Size-dependent bacterial growth inhibition and mechanism of antibacterial activity of zinc oxide nanoparticles. Langmuir 2011, 27, 4020–4028. [Google Scholar] [CrossRef]
- Zhang, X.; Qin, J.; Xue, Y.; Yu, P.; Zhang, B.; Wang, L.; Liu, R. Effect of aspect ratio and surface defects on the photocatalytic activity of ZnO nanorods. Sci. Rep. 2014, 4, 4596. [Google Scholar] [CrossRef]
- Stoimenov, P.K.; Klinger, R.L.; Marchin, G.L.; Klabunde, K.J. Metal oxide nanoparticles as bactericidal agents. Langmuir 2002, 18, 6679–6686. [Google Scholar] [CrossRef]
- Jalal, R.; Goharshadi, E.K.; Abareshi, M.; Moosavi, M.; Yousefi, A.; Nancarrow, P. ZnO nanofluids: Green synthesis, characterization, and antibacterial activity. Mater. Chem. Phys. 2010, 121, 198–201. [Google Scholar] [CrossRef]
- Lakshmi Prasanna, V.; Vijayaraghavan, R. Insight into the mechanism of antibacterial activity of ZnO: Surface defects mediated reactive oxygen species even in the dark. Langmuir 2015, 31, 9155–9162. [Google Scholar] [CrossRef] [PubMed]
- Xu, X.; Chen, D.; Yi, Z.; Jiang, M.; Wang, L.; Zhou, Z.; Fan, X.; Wang, Y.; Hui, D. Antimicrobial mechanism based on H2O2 generation at oxygen vacancies in ZnO crystals. Langmuir 2013, 29, 5573–5580. [Google Scholar] [CrossRef] [PubMed]
- Sirelkhatim, A.; Mahmud, S.; Seeni, A.; Kaus, N.H.M.; Ann, L.C.; Bakhori, S.K.M.; Hasan, H.; Mohamad, D. Review on zinc oxide nanoparticles: Antibacterial activity and toxicity mechanism. Nano-Micro Lett. 2015, 7, 219–242. [Google Scholar] [CrossRef] [PubMed]
- Badwaik, V.D.; Vangala, L.M.; Pender, D.S.; Willis, C.B.; Aguilar, Z.P.; Gonzalez, M.S.; Paripelly, R.; Dakshinamurthy, R. Size-dependent antimicrobial properties of sugar-encapsulated gold nanoparticles synthesized by a green method. Nanoscale Res. Lett. 2012, 7, 623. [Google Scholar] [CrossRef]
- Zheng, K.; Setyawati, M.I.; Leong, D.T.; Xie, J. Antimicrobial gold nanoclusters. ACS Nano 2017, 11, 6904–6910. [Google Scholar] [CrossRef]
- Kumar, P.; Chiu, Y.-H.; Deng, Z.-I.; Kumar, U.; Chen, K.-L.; Huang, W.-M.; Wu, C.-H. Surface modification of ZnO nanopillars to enhance the sensitivity towards methane: The studies of experimental and first-principle simulation. Appl. Surf. Sci. 2021, 568, 150817. [Google Scholar] [CrossRef]
- Mohd Yusof, H.; Abdul Rahman, N.A.; Mohamad, R.; Hasanah Zaidan, U.; Samsudin, A.A. Antibacterial potential of biosynthesized zinc oxide nanoparticles against poultry-associated foodborne pathogens: An in vitro study. Animals 2021, 11, 2093. [Google Scholar] [CrossRef]
- Chauhan, A.; Verma, R.; Kumari, S.; Sharma, A.; Shandilya, P.; Li, X.; Batoo, K.M.; Imran, A.; Kulshrestha, S.; Kumar, R. Photocatalytic dye degradation and antimicrobial activities of Pure and Ag-doped ZnO using Cannabis sativa leaf extract. Sci. Rep. 2020, 10, 1–16. [Google Scholar] [CrossRef]
- Zare, M.; Namratha, K.; Alghamdi, S.; Mohammad, Y.H.E.; Hezam, A.; Zare, M.; Drmosh, Q.A.; Byrappa, K.; Chandrashekar, B.N.; Ramakrishna, S. Novel green biomimetic approach for synthesis of ZnO-Ag nanocomposite; antimicrobial activity against food-borne pathogen, biocompatibility and solar photocatalysis. Sci. Rep. 2019, 9, 1–15. [Google Scholar] [CrossRef]
- Al-Mohaimeed, A.M.; Al-Onazi, W.A.; El-Tohamy, M.F. Multifunctional eco-friendly synthesis of ZnO nanoparticles in biomedical applications. Molecules 2022, 27, 579. [Google Scholar] [CrossRef]
- Melaiye, A.; Youngs, W.J. Silver and Its Application as an Antimicrobial Agent; Taylor & Francis: Tokyo, Japan, 2005; Volume 15, pp. 125–130. [Google Scholar]
- Lewinski, N.; Colvin, V.; Drezek, R. Cytotoxicity of nanoparticles. Small 2008, 4, 26–49. [Google Scholar] [CrossRef] [PubMed]

| Sample | Population 1 | Population 2 | P.D.I. | ζ/mV | ||
|---|---|---|---|---|---|---|
| % | dh/nm | % | dh/nm | |||
| Z1 | 39 | 23 | 61 | 100 | 0.446 | 17.77 ± 1.41 |
| ZA1 | 47 | 23 | 53 | 105 | 0.493 | −4.34 ± 0.80 |
| Z2 | 31 | 33 | 69 | 115 | 0.580 | 14.09 ± 1.24 |
| ZA2 | 35 | 33 | 65 | 121 | 0.589 | −5.18 ± 0.91 |
| Samples | Z1 | Z2 | ZA1 | ZA2 | ||
|---|---|---|---|---|---|---|
| ZI (mm)/E. coli | 8 | 7 | 14 | 12 | ||
| ZI(mm)/S.aureus | 6 | 6 | 14 | 10 | ||
| Sum | 14 | 13 | 28 | 22 | ||
| Average | 7 | 6.5 | 14 | 11 | ||
| Variance | 2 | 0.5 | 0 | 2 | ||
| Source of Variation | SS | df | MS | F | p-Value | F crit |
| Between Groups | 75.375 | 3 | 25.125 | 22.3333 | 0.0058 | 6.5913 |
| Within Groups | 4.5 | 4 | 1.125 | |||
| Total | 79.875 | 7 | ||||
Publisher’s Note: MDPI stays neutral with regard to jurisdictional claims in published maps and institutional affiliations. |
© 2022 by the authors. Licensee MDPI, Basel, Switzerland. This article is an open access article distributed under the terms and conditions of the Creative Commons Attribution (CC BY) license (https://creativecommons.org/licenses/by/4.0/).
Share and Cite
Dediu, V.; Busila, M.; Tucureanu, V.; Bucur, F.I.; Iliescu, F.S.; Brincoveanu, O.; Iliescu, C. Synthesis of ZnO/Au Nanocomposite for Antibacterial Applications. Nanomaterials 2022, 12, 3832. https://doi.org/10.3390/nano12213832
Dediu V, Busila M, Tucureanu V, Bucur FI, Iliescu FS, Brincoveanu O, Iliescu C. Synthesis of ZnO/Au Nanocomposite for Antibacterial Applications. Nanomaterials. 2022; 12(21):3832. https://doi.org/10.3390/nano12213832
Chicago/Turabian StyleDediu, Violeta, Mariana Busila, Vasilica Tucureanu, Florentina Ionela Bucur, Florina Silvia Iliescu, Oana Brincoveanu, and Ciprian Iliescu. 2022. "Synthesis of ZnO/Au Nanocomposite for Antibacterial Applications" Nanomaterials 12, no. 21: 3832. https://doi.org/10.3390/nano12213832
APA StyleDediu, V., Busila, M., Tucureanu, V., Bucur, F. I., Iliescu, F. S., Brincoveanu, O., & Iliescu, C. (2022). Synthesis of ZnO/Au Nanocomposite for Antibacterial Applications. Nanomaterials, 12(21), 3832. https://doi.org/10.3390/nano12213832

